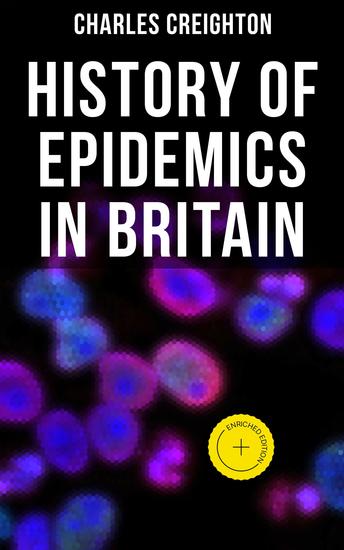

History of Epidemics in Britain - Enriched edition
Charles Creighton
Casa editrice: Musaicum Books
Sinossi
Charles Creighton's 'History of Epidemics in Britain' delves into the fascinating history of disease outbreaks within the British Isles. Creighton's meticulous research and detailed analysis provide a comprehensive overview of how various epidemics, such as the Black Death and the Great Plague of London, have shaped the country's history and impacted its people. Written in a scholarly yet accessible style, this book offers valuable insights into the social, political, and medical responses to epidemics throughout British history, making it a essential read for anyone interested in public health or British history. Creighton's attention to detail and critical analysis of primary sources make this book a valuable addition to the study of epidemiology and the history of medicine. By examining past epidemics and their effects on society, 'History of Epidemics in Britain' sheds light on the ways in which disease outbreaks have shaped the course of British history and influenced the development of public health policies. In this enriched edition, we have carefully created added value for your reading experience: - A succinct Introduction situates the work's timeless appeal and themes. - The Synopsis outlines the central plot, highlighting key developments without spoiling critical twists. - A detailed Historical Context immerses you in the era's events and influences that shaped the writing. - A thorough Analysis dissects symbols, motifs, and character arcs to unearth underlying meanings. - Reflection questions prompt you to engage personally with the work's messages, connecting them to modern life. - Hand‐picked Memorable Quotes shine a spotlight on moments of literary brilliance. - Interactive footnotes clarify unusual references, historical allusions, and archaic phrases for an effortless, more informed read.














